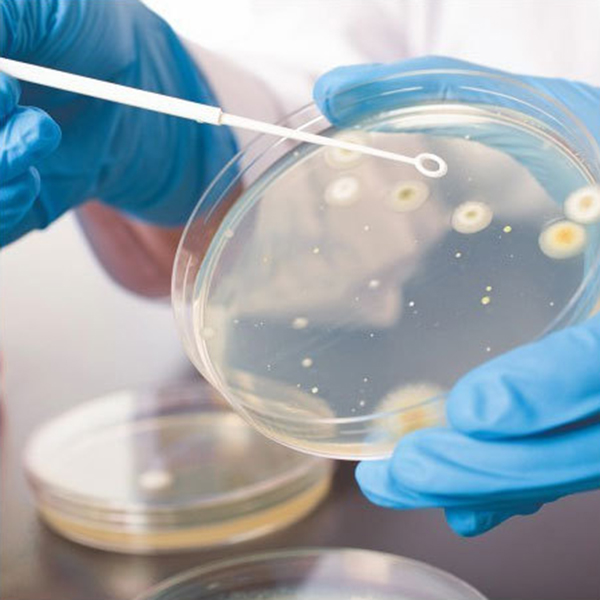

We are professional
ATS Medical Supplies
[vc_row][vc_column][vc_column_text]ATS Medical Supplies Trading LLC, your trusted partner in providing high-quality medical equipment and supplies. Established in 2020, we are a dynamic and forward-thinking company dedicated to delivering innovative solutions to healthcare professionals and institutions. Our mission is to contribute to the well-being of patients by offering a comprehensive range of cutting-edge medical devices and supplies.
We understand the evolving needs of the healthcare industry, and we are committed to staying at the forefront of advancements. Whether you are a hospital, clinic, or healthcare provider, our extensive product portfolio caters to a wide spectrum of medical specialties.[/vc_column_text][/vc_column][/vc_row]